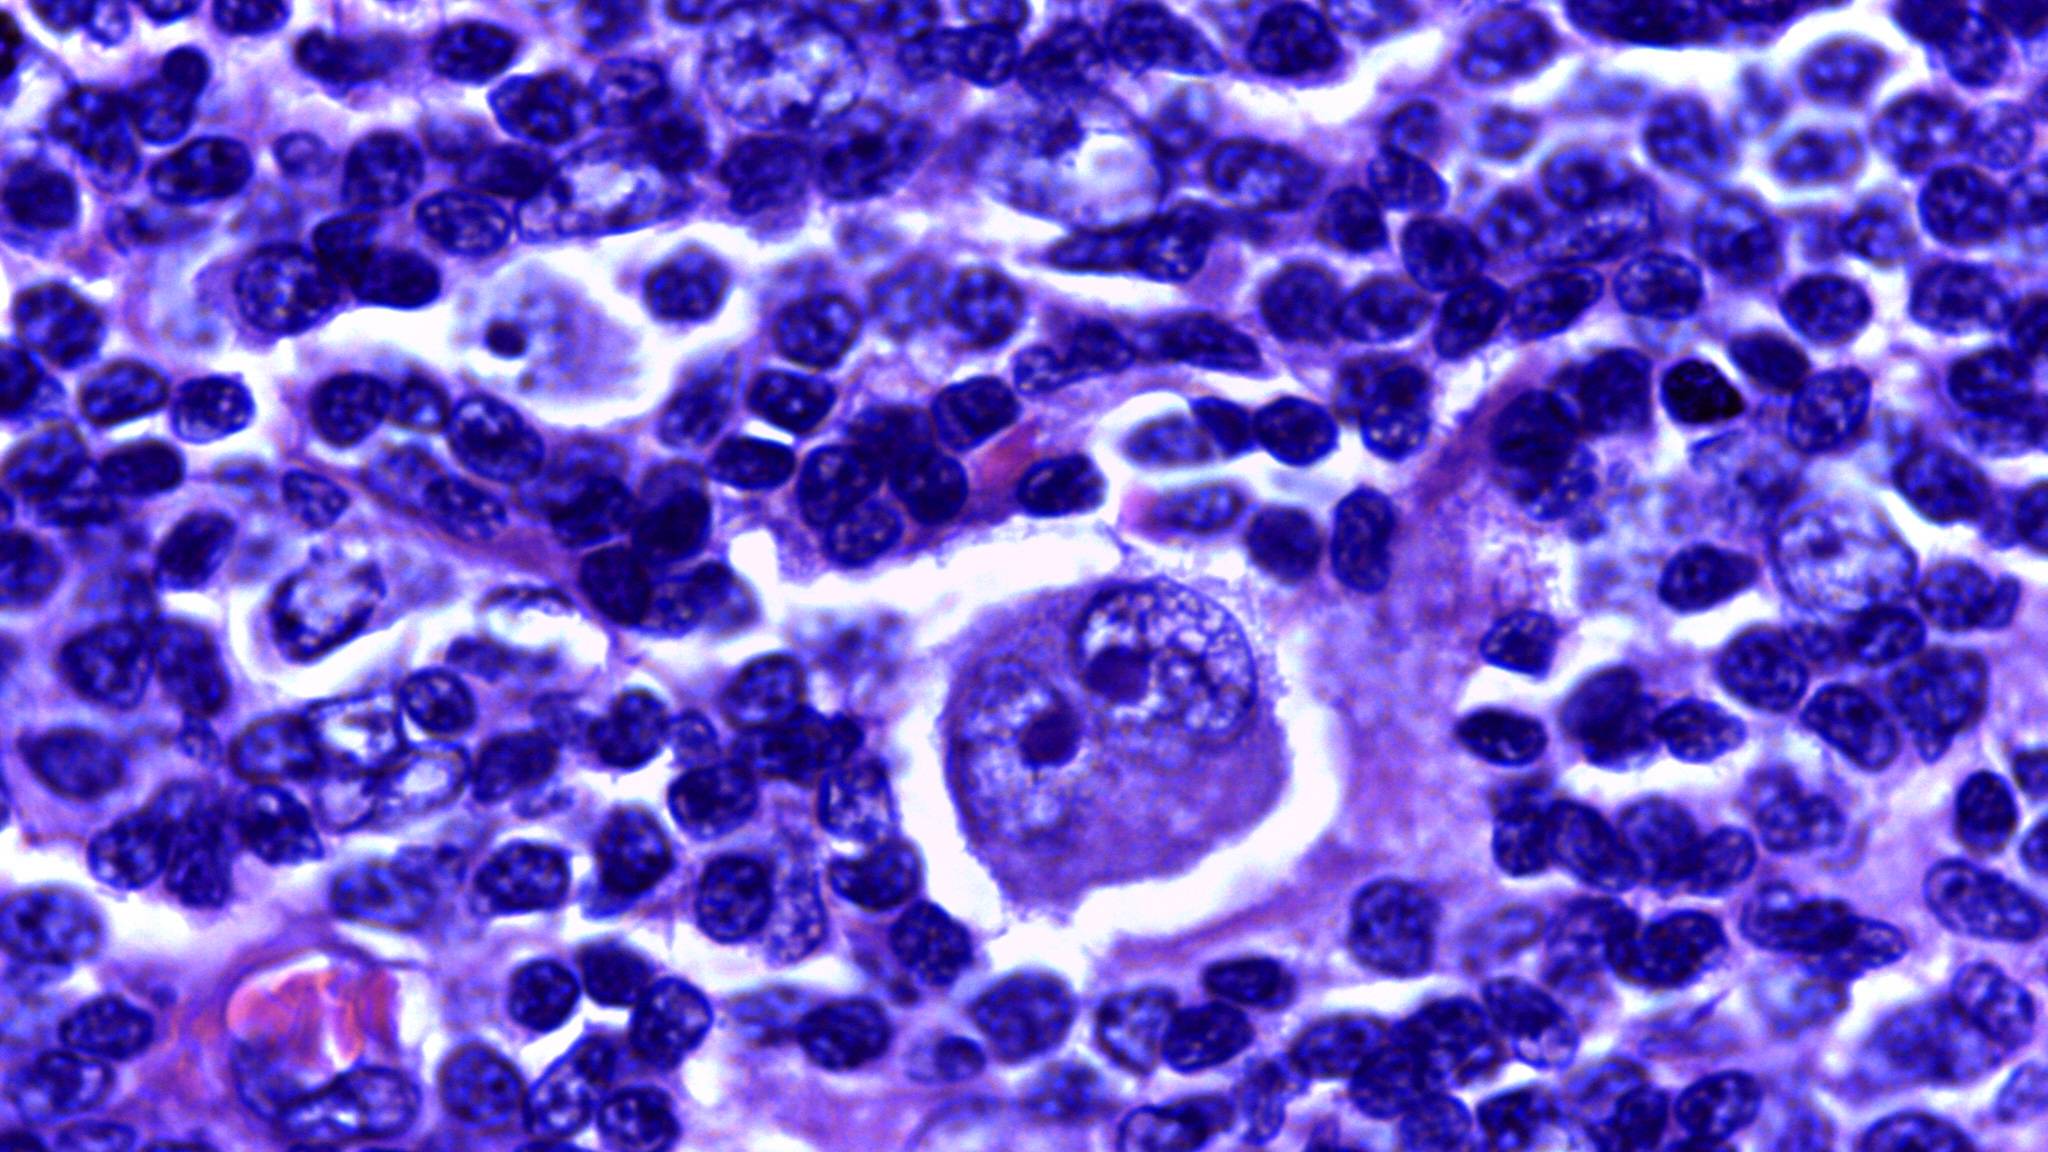
Bệnh giảm tiểu cầu có thể làm tăng nguy cơ mắc các bệnh ác tính về máu như u lympho Hodgkin

Tiểu cầu là thành phần quan trọng của máu có vai trò cầm máu và bảo vệ cơ thể trước nguy cơ xuất huyết. Khi số lượng tiểu cầu giảm xuống dưới ngưỡng bình thường, người bệnh có thể xuất hiện nhiều triệu chứng bất thường từ nhẹ đến nghiêm trọng. Trên thực tế, không ít người hoang mang khi nhận kết quả xét nghiệm tiểu cầu thấp và lo sợ mình đang mắc bệnh ác tính về máu. Tuy nhiên, không phải mọi trường hợp đều mang ý nghĩa nguy hiểm như vậy.
Giảm tiểu cầu có phải là ung thư máu không?
Giảm tiểu cầu không phải là ung thư máu. Tuy nhiên, một số bệnh ung thư máu có thể gây ra tình trạng giảm tiểu cầu. Điều này dễ khiến nhiều người nhầm lẫn giữa hai khái niệm.
Ung thư máu bao gồm các bệnh lý ác tính của hệ tạo máu như bệnh bạch cầu và u lympho. Trong những trường hợp này, các tế bào ác tính tăng sinh quá mức trong tủy xương và lấn át các tế bào máu bình thường. Khi đó, quá trình sinh tiểu cầu bị ức chế dẫn đến số lượng tiểu cầu trong máu ngoại vi giảm xuống.
Ngoài bản thân bệnh ung thư máu, các phương pháp điều trị ung thư cũng có thể làm tiểu cầu giảm. Hóa trị và xạ trị là hai nguyên nhân điển hình. Thuốc hóa chất và tia xạ không chỉ tiêu diệt tế bào ung thư mà còn ảnh hưởng đến tế bào lành trong tủy xương khiến khả năng sinh tiểu cầu bị suy giảm tạm thời hoặc kéo dài.
Như vậy, giảm tiểu cầu có thể xuất hiện trong quá trình mắc hoặc điều trị ung thư máu nhưng bản thân việc giảm tiểu cầu không đồng nghĩa với việc người bệnh đang mắc ung thư. Rất nhiều trường hợp tiểu cầu thấp hoàn toàn không liên quan đến bệnh lý ác tính.

Khi nào giảm tiểu cầu không phải là ung thư máu?
Trên thực tế, phần lớn các ca giảm tiểu cầu gặp trong cộng đồng xuất phát từ những nguyên nhân lành tính hoặc bệnh lý không ác tính. Đây là điều người bệnh cần đặc biệt lưu ý để tránh tâm lý hoang mang không cần thiết.
Rối loạn tự miễn
Một trong những nguyên nhân thường gặp nhất là các bệnh tự miễn. Hệ miễn dịch nhầm lẫn tiểu cầu là yếu tố có hại và tạo kháng thể phá hủy tiểu cầu. Điển hình là bệnh xuất huyết giảm tiểu cầu miễn dịch và lupus ban đỏ hệ thống. Trong các trường hợp này, tủy xương vẫn có khả năng sinh tiểu cầu bình thường nhưng tiểu cầu bị phá hủy sớm trong tuần hoàn.
Nhiễm trùng
Nhiều bệnh nhiễm virus và vi khuẩn có thể gây giảm tiểu cầu tạm thời. Viêm gan B, viêm gan C, HIV, sốt xuất huyết Dengue, quai bị hoặc nhiễm khuẩn huyết đều có thể làm tiểu cầu giảm do ức chế tủy xương hoặc tăng tiêu thụ tiểu cầu. Khi nhiễm trùng được kiểm soát, số lượng tiểu cầu thường hồi phục.

Tác dụng phụ của thuốc
Một số thuốc có thể ảnh hưởng đến quá trình sinh hoặc phá hủy tiểu cầu như kháng sinh nhóm beta lactam, thuốc chống co giật, thuốc tim mạch hoặc heparin. Trong những trường hợp này, việc ngừng hoặc thay thế thuốc theo chỉ định bác sĩ có thể giúp cải thiện tình trạng.
Rượu bia và độc chất
Uống nhiều rượu kéo dài làm suy giảm chức năng tủy xương và giảm sản xuất tiểu cầu. Ngoài ra, việc tiếp xúc với hóa chất độc hại như benzen, asen hoặc thuốc trừ sâu cũng có thể gây giảm tiểu cầu mà không liên quan đến ung thư.
Rối loạn tủy xương không ác tính
Thiếu máu bất sản và một số rối loạn tủy xương khác làm giảm khả năng sinh các dòng tế bào máu bao gồm tiểu cầu. Đây là bệnh lý nghiêm trọng nhưng không phải ung thư máu.

Các hội chứng tiêu thụ tiểu cầu
Xuất huyết giảm tiểu cầu huyết khối và đông máu nội mạch rải rác là hai tình trạng hiếm gặp khiến tiểu cầu bị tiêu thụ nhanh chóng. Tiểu cầu giảm sâu trong thời gian ngắn và cần được xử lý cấp cứu.
Trong tất cả những trường hợp trên, giảm tiểu cầu chỉ là hậu quả của một rối loạn khác. Tuy nhiên, các dấu hiệu như bầm tím tự nhiên, chảy máu cam kéo dài, rong kinh hoặc xuất huyết dưới da vẫn cần được đánh giá y tế sớm.
Bệnh giảm tiểu cầu có thể phát triển thành ung thư không?
Một số nghiên cứu cho thấy, xuất huyết giảm tiểu cầu nguyên phát có thể làm tăng nguy cơ mắc một số bệnh ung thư. Nguyên nhân được cho là liên quan đến rối loạn miễn dịch kéo dài làm suy giảm khả năng nhận diện và tiêu diệt tế bào tiền ác tính của cơ thể.
Bên cạnh đó, một số phương pháp điều trị như thuốc điều hòa miễn dịch, corticosteroid hoặc chất chủ vận thụ thể TPO cũng được ghi nhận có liên quan đến nguy cơ ung thư trong một số trường hợp nhất định.
Các báo cáo ghi nhận nguy cơ tăng của nhiều loại ung thư như ung thư gan, phổi, dạ dày, thận, buồng trứng và vú ở nhóm bệnh nhân này. Đặc biệt, nguy cơ ung thư gan có thể cao hơn rõ rệt so với dân số chung. Ngoài ra, nguy cơ mắc các bệnh ác tính về máu như u lympho Hodgkin, u lympho không Hodgkin và bệnh bạch cầu cũng được ghi nhận tăng nhẹ.
Tuy nhiên, cần nhấn mạnh rằng nguy cơ này không xảy ra ở tất cả bệnh nhân và đa số người mắc giảm tiểu cầu vẫn không phát triển thành ung thư nếu được theo dõi và điều trị đúng cách.
Phải làm gì khi bị giảm tiểu cầu?
Khi phát hiện tiểu cầu thấp, điều quan trọng nhất không phải là lo lắng về ung thư mà là xác định chính xác nguyên nhân gây giảm tiểu cầu.
Bác sĩ sẽ chỉ định các xét nghiệm cần thiết như công thức máu, xét nghiệm kháng thể tiểu cầu, tủy đồ hoặc sinh thiết tủy xương trong những trường hợp nghi ngờ. Đồng thời, việc khai thác tiền sử bệnh lý dùng thuốc nhiễm trùng và lối sống đóng vai trò rất quan trọng.
Việc điều trị giảm tiểu cầu phụ thuộc hoàn toàn vào nguyên nhân. Nếu nguyên nhân không liên quan đến ung thư, phác đồ sẽ tập trung xử lý bệnh nền như kiểm soát rối loạn miễn dịch, điều trị nhiễm trùng hoặc điều chỉnh thuốc đang sử dụng. Trong những trường hợp tiểu cầu giảm nặng kèm xuất huyết, bệnh nhân có thể được chỉ định truyền tiểu cầu để đảm bảo an toàn.

Giảm tiểu cầu có phải là ung thư máu? Giảm tiểu cầu là một tình trạng y khoa có nhiều nguyên nhân khác nhau và không đồng nghĩa với ung thư máu. Việc hiểu đúng bản chất giúp người bệnh tránh hoang mang và chủ động thăm khám sớm. Khi được chẩn đoán và điều trị đúng nguyên nhân, đa số trường hợp giảm tiểu cầu đều có thể kiểm soát tốt và hạn chế biến chứng nguy hiểm.
:format(webp)/470051785_8767135473405056_691967411107495592_n_6b2bbff755.png)
:format(webp)/467434554_545745841560409_1066418224364723785_n_560a494f9c.png)
/benh_a_z_tieu_cau_thap_0_4e5cf978a5.jpg)
/xo_gan_giam_tieu_cau_co_nguy_hiem_khong_nguyen_nhan_gay_ra_tinh_trang_nay_51ac0a4fbc.png)
/benh_tang_tieu_cau_khong_nen_an_gi_thuc_pham_can_han_che_2_586b8c6739.png)
/xet_nghiem_ung_thu_mau_o_tre_em_nhung_thong_tin_quan_trong_ba_me_can_biet_0_7a5832b389.png)
/nhung_dau_hieu_ung_thu_mau_o_tre_em_ba_me_can_biet_0_f3f3ef318d.png)